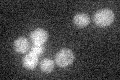
YLR024C
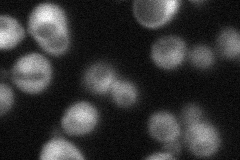
YLR024C
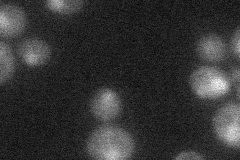
YLR024C
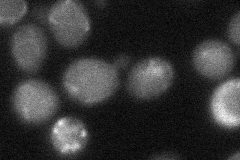
YLR024C
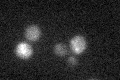
YLR024C

View description
Cytoplasmic ubiquitin-protein ligase (E3); required for ubiquitylation of Rpn4p; mediates formation of a Mub1p-Ubr2p-Rad6p complex
Localization:
Intensity:
Fold change:
Significance:
-
C’ GFP library in SD
below threshold14.95 -
N' NOP1pr-GFP in SD
cytosol,nucleus35.2483 -
N' TEF2pr-mCherry in SD
nucleus17.0497 -
N' NATIVEpr-GFP in SD

below threshold23.8039 -
N' TEF2pr-VC and Cyto-VN in SD
below threshold26.7301 -
C’ GFP library in SD+DTT

cytosol12.950.86No -
C’ GFP library in SD+H2O2

cytosol15.481.03No -
C’ GFP library in Starvation Media
cytosol19.691.31No -
C’ GFP library on the background of Pup2-DaMP

below threshold -
C’ GFP library on the background of CCT mutant

below threshold16.68621.11515No
